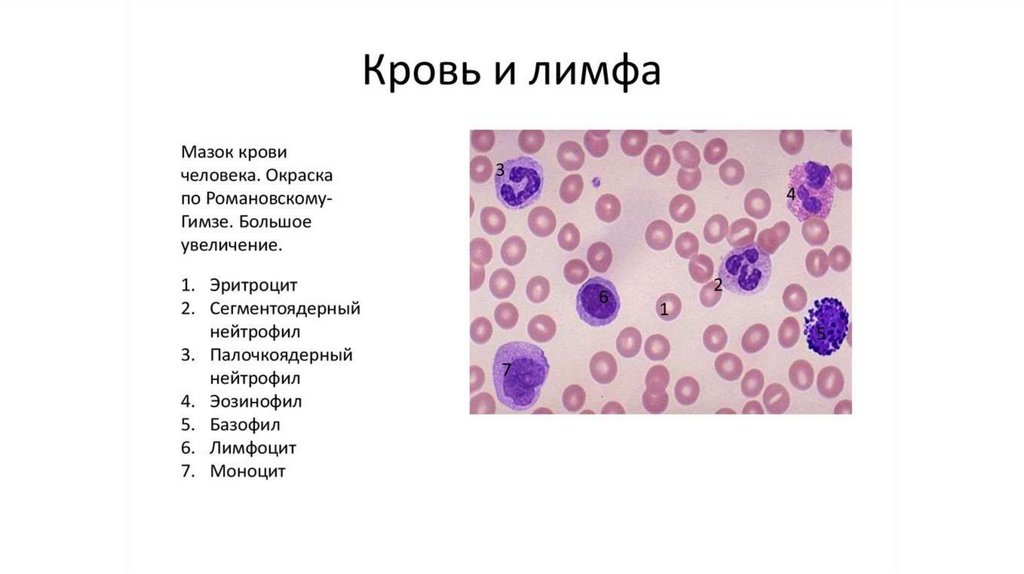

Похожие презентации:
Анатомия и физиология человека
1.
Анатомия (от греч. Anatemno - рассекаю) наука, изучающая форму, строениечеловеческого организма и составляющих его
органов и систем.
Физиология (от греч. Phisis – природа) – наука,
изучающая процессы жизнедеятельности
целостного организма, его органов, тканей,
клеток.
2.
Организм - это высшее единство белковыхтел, способных к обмену веществ с
окружающей средой, к росту и размножению.
Это исторически сложившаяся, целостная, все
время меняющаяся система, имеющая свое
особое строение и развитие. Организм живет
лишь в определенных условиях окружающей
среды, к которым он приспособлен и вне
которых он не может существовать.
3.
4.
5.
6.
7.
8.
Строение клеткиУльтрамикроскопическое строение клетки:
1 - цитолемма (плазматическая мембрана);
2 - связь клеточной оболочки (цитолеммы)
с мембранами эндоплазматической сети; 3
- пиноцитозные пузырьки; 4 - центросома
(клеточный центр; цитоцентр); 5 гиалоплазма; 6 - эндоплазматическая сеть:
6а - мембрана зернистой сети, 6б рибосомы; 7 - незернистая (гладкая)
эндоплазматическая сеть; 8 - связь
перинуклеарного пространства с
полостями эндоплазматической сети; 9 ядерные поры; 10 - секреторные вакуоли;
11 - внутренний сетчатый аппарат
(комплекс Гольджи); 12 - митохондрия; 13 ядрышко; 14 - ядро; 15 - лизосомы; 16 - три
последовательные стадии фагоцитоза
9.
Формы клеток: 1 — нервная; 2 — эпителиальная; 3 —соединителытотканная; 4 — гладкая мышечная; 5— эритроцит; 6—
сперматозоид; 7—яйцеклетка
10.
11.
12.
13.
14.
15.
16.
17.
18.
19.
20.
21.
22.
23.
24.
25.
Кость (os) — это орган, являющийсякомпонентом системы органов опоры и
движения, имеющий типичную форму и
строение, характерную архитектонику сосудов и
нервов, построенный преимущественно из
костной ткани, покрытый снаружи надкостницей
(periosteum) и содержащий внутри костный мозг
(medulla osseum). Каждая кость имеет
определенную форму, величину и положение в
теле человека.
26.
27.
28.
29.
30.
31.
32.
33.
34.
35.
36.
37.
38.
Мышца (лат. – musculus), как орган состоит изпоперечно-полосатой мышечной ткани, рыхлой и
плотной соединительной ткани, сосудов и
нервов, имеет специфическую форму и
выполняет функцию сокращения.

Биология
Биология








